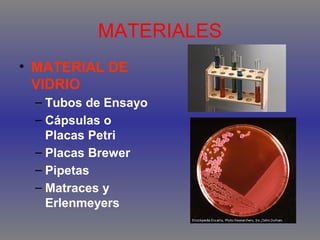
MATERIALES
• MATERIAL DE
VIDRIO
– Tubos de Ensayo
– Cápsulas o
Placas Petri
– Placas Brewer
– Pipetas
– Matraces y
Erlenmeyers

Este documento describe las funciones y capacidades de un laboratorio bacteriológico, incluyendo varios laboratorios clínicos especializados, los niveles de bioseguridad del 1 al 4, los materiales y equipos utilizados como vidrio, centrífugas e incubadoras, y los procedimientos de control de calidad para medios de cultivo y el análisis bacteriológico de aguas, con un límite de 5 gérmenes por 100 ml.